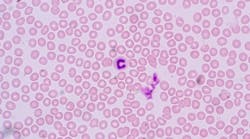

Autoimmune diseases: What you need to know for your patients
Autoimmune disease refers to complications of the immune system, which is programed to fight off viruses, pathogenic bacteria, and other types of infection in the body.
There are more than 80 types of autoimmune diseases. “Autoimmune diseases are the third most common category of disease in the United States after cancer and heart disease; they affect approximately 5%-8% of the population or 14-22 million persons.”1
One of the main functions of the immune system is to protect the body by responding to invading microorganisms, such as viruses or bacteria, by producing antibodies or sensitized lymphocytes (types of white blood cells). Under normal conditions, an immune response cannot be triggered against the cells of one’s own body. However, in an individual with an autoimmune disease, the body’s own cells are recognized mistakenly as foreign and attack themselves. Autoimmune diseases can affect almost any part of the body and can be difficult to diagnose, as some autoimmune disorders share similar symptoms and may not present until later in life. As more advanced diagnostics and awareness are developed, it is important for the dental hygienist to understand how these diseases may affect the course of dental treatment and home care, as well as the rest of the body.
Most autoimmune diseases cause the traditional signs of inflammation: redness, heat, pain, and swelling. The symptoms may depend on the body part affected, such as the joints, thyroid, or skin. Joints experience symptoms such as pain and stiffness. Thyroid symptoms may present as tiredness, weight gain, or muscle aches. Visual symptoms present on the skin in the form of a rash, blister, or color change.2 Although the causation is idiopathic, ethnicity, genetics, environment, and exposure to infection may all play unique roles in development of an autoimmune disease. Environmental factors, “including viral infections, smoking, and low vitamin D levels are also known to trigger such diseases in susceptible people.”3
Who is at risk?
Common types of autoimmune diseases include type 1 diabetes, lupus, celiac disease, Crohn’s disease, endometriosis, psoriasis, rheumatoid arthritis, Grave’s disease, narcolepsy, and multiple sclerosis. “Autoimmune diseases affect approximately 8% of the population, 78% of whom are women.”1 Statistics show that “women get autoimmune diseases at a rate of about 2 to 1 compared to men—6.4 percent of women vs. 2.7 percent of men.”4 Often onset of symptoms and diagnosis occurs during childbearing years, ages 14 to 44.4 The reasons for the higher prevalence in women are still unknown; however, “scientists speculate that women’s enhanced immune systems may make them more vulnerable to autoimmune disorders, along with hormonal changes.”5 Autoimmune diseases are among the top 10 killers of women over 60 years old. This may be due to quiescent symptoms over several years. The effect of gender on severity varies among autoimmune diseases, and the precise interaction between male and female sex hormones and the innate immune response requires more research.
What causes autoimmune diseases?
Some autoimmune diseases are more common among certain ethnic groups. This may be due to a genetic polymorphism, the class III region, situated in the human major histocompatibility locus.7 African Americans, American Indians, and Latinos are more likely to develop autoimmune diseases compared to Caucasians.7 Studies have shown that the tendency to develop autoimmune disorders can be inherited. “Autoimmune diseases tend to cluster in families and in individuals (a person with one autoimmune disease is more likely to get another), which indicates that common mechanisms are involved in disease susceptibility.”1
There is some evidence that exposure to certain things in the environment may increase the risk of developing autoimmune disorders. Research shows that exposure to some medications (for example, procainamide or hydralazine) and certain metals (for example, mercury, gold, or silver) may be associated with the development of autoimmune disorders. (8) Research is still ongoing as environmental factors are studied for possible causation.
Are autoimmune diseases caused by infections?
There is mounting evidence that genetically susceptible people who have had certain bacterial and viral infections may be at risk for some types of autoimmune disorders. Researchers believe that tumor necrosis factor (TNF), a cytokine (cell signaling molecule), has a role to play in the development of autoimmune diseases. (7) “TNF is a cytokine produced as one of the first responders to infection but may also play a role in the pathogenesis of autoimmune disorders. The role of TNF in rheumatoid arthritis has been well documented and there are now new therapeutic agents available for treatment based on these studies.” (7)“A body of circumstantial evidence links diabetes, multiple sclerosis, myocarditis, and many other autoimmune diseases with preceding infections.” (1)“Many different microorganisms have been associated with a single autoimmune disease, which indicates that more than one infectious agent can induce the same disease through a similar mechanism.” (1) It is challenging to link an infection to the causation of an autoimmune disease since infections generally occur well before the onset of any symptoms of an autoimmune disease. While an innate response to the infection is present within a few hours, chronic disease symptoms may not appear until weeks or months after the initial infection.
Is periodontal disease an autoimmune disease?
“Periodontal disease is characterized by localized infections and inflammatory conditions that directly affect teeth and supporting structures, which [is] the major cause of tooth loss.” (9)Numerous factors are involved with the pathogenesis and progression of the disease. These include the involvement of several anaerobic bacteria and viruses including herpes simplex, varicella-zoster, cytomegalovirus, and Epstein-Barr.Should we also classify periodontal disease as an autoimmune disease? “Three aspects of the phenomenon warrant consideration: firstly, the evidence which has accumulated over the past in relation to autoimmunity; secondly, the mechanism by which such autoimmunity may arise; and lastly, the possible role of such an abnormal immune response in the natural history of the disease.”9
We know autoimmune diseases display classic patterns of exacerbation and remission. Periodontal disease shares in this cyclical pattern along with other factors such as genetic predisposition seen in the human leukocyte antigen or HLA system of immune response.9 The HLA system probably contains immune response (Ir) genes, which control the response to various antigens. It is proposed that absence of a specific Ir gene could lead to chronic infection. 9
Researchers have previously found that individuals with chronic periodontal disease show evidence of antibodies to collagen types I and III. The immune reaction to collagen appears to be more common in persons with other autoimmune diseases, particularly type I diabetes.10
Certainly, “periodontal disease being a chronic inflammatory disease has a complex etiopathogenesis which still remains not completely understood.”9 With continued advances in research and diagnostics, perhaps someday we will include periodontal disease as an autoimmune disease.
Editor's note: This article first appeared in RDH eVillage. Click here to subscribe.
References
1. Fairweather D, Rose NR. Women and autoimmune diseases. Emerg Infect Dis. 2004;10(11):2005-2011.
2. Autoimmune diseases. NIH National Institute of Arthritis and Musculoskeletal and Skin Diseases website. www.niams.nih.gov/health-topics/autoimmune-diseases.
3. Shaking out clues to autoimmune disease. National Institutes of Health website. https://www.nih.gov/news-events/nih-research-matters/shaking-out-clues-autoimmune-disease. Published March 18, 2013.
4. Autoimmune diseases. Energicx website. https://energicxusa.com/autoimmune-diseases/.
5. McCoy K. Risk factors for autoimmune disorders. https://www.everydayhealth.com/autoimmune-disorders/autoimmune-risk-factors.aspx.
6. Ngo ST, Steyn FJ, McCombe PA. Gender differences in autoimmune disease. Front Neuroendocrinol. 2014;35(3):347-369.
7. Moulds JM. Ethnic diversity of class III genes in autoimmune disease. Front Biosci. 2001;6:D986-91.
8. Pollard KM, Hultman P, Kono DH. Toxicology of autoimmune diseases. Chem Res Toxicol. 2010 Mar 15; 23(3): 455–466.
9. Nair S, Faizuddin M, Dharmapalan J. Role of autoimmune responses in periodontal disease. Autoimmune Dis. 2014; 2014: 596824.
10. Moore E. Is periodontal disease an autoimmune disorder? Elaine Moore website. http://www.elaine-moore.com/Articles/AutoimmuneDiseasesArticles/IsPeriodontalDiseaseanAutoimmuneDisorder/tabid/286/Default.aspx. Published January 5, 2011.
About the Author
Kathryn Kupczyk, BSDH
Kathryn Kupczyk, BSDH, attended DePaul University and completed her bachelors of science in biology with a concentration in microbiology where she performed and presented at several research symposiums in Chicago. She graduated from the University of Michigan School of Dentistry with her bachelor of dental hygiene degree, and a minor in business from Ross School of Business. Currently, Kathryn is an independent product consultant, member of Sigma Pi Alpha, working full time in private practice, and a published author in RDH magazine.